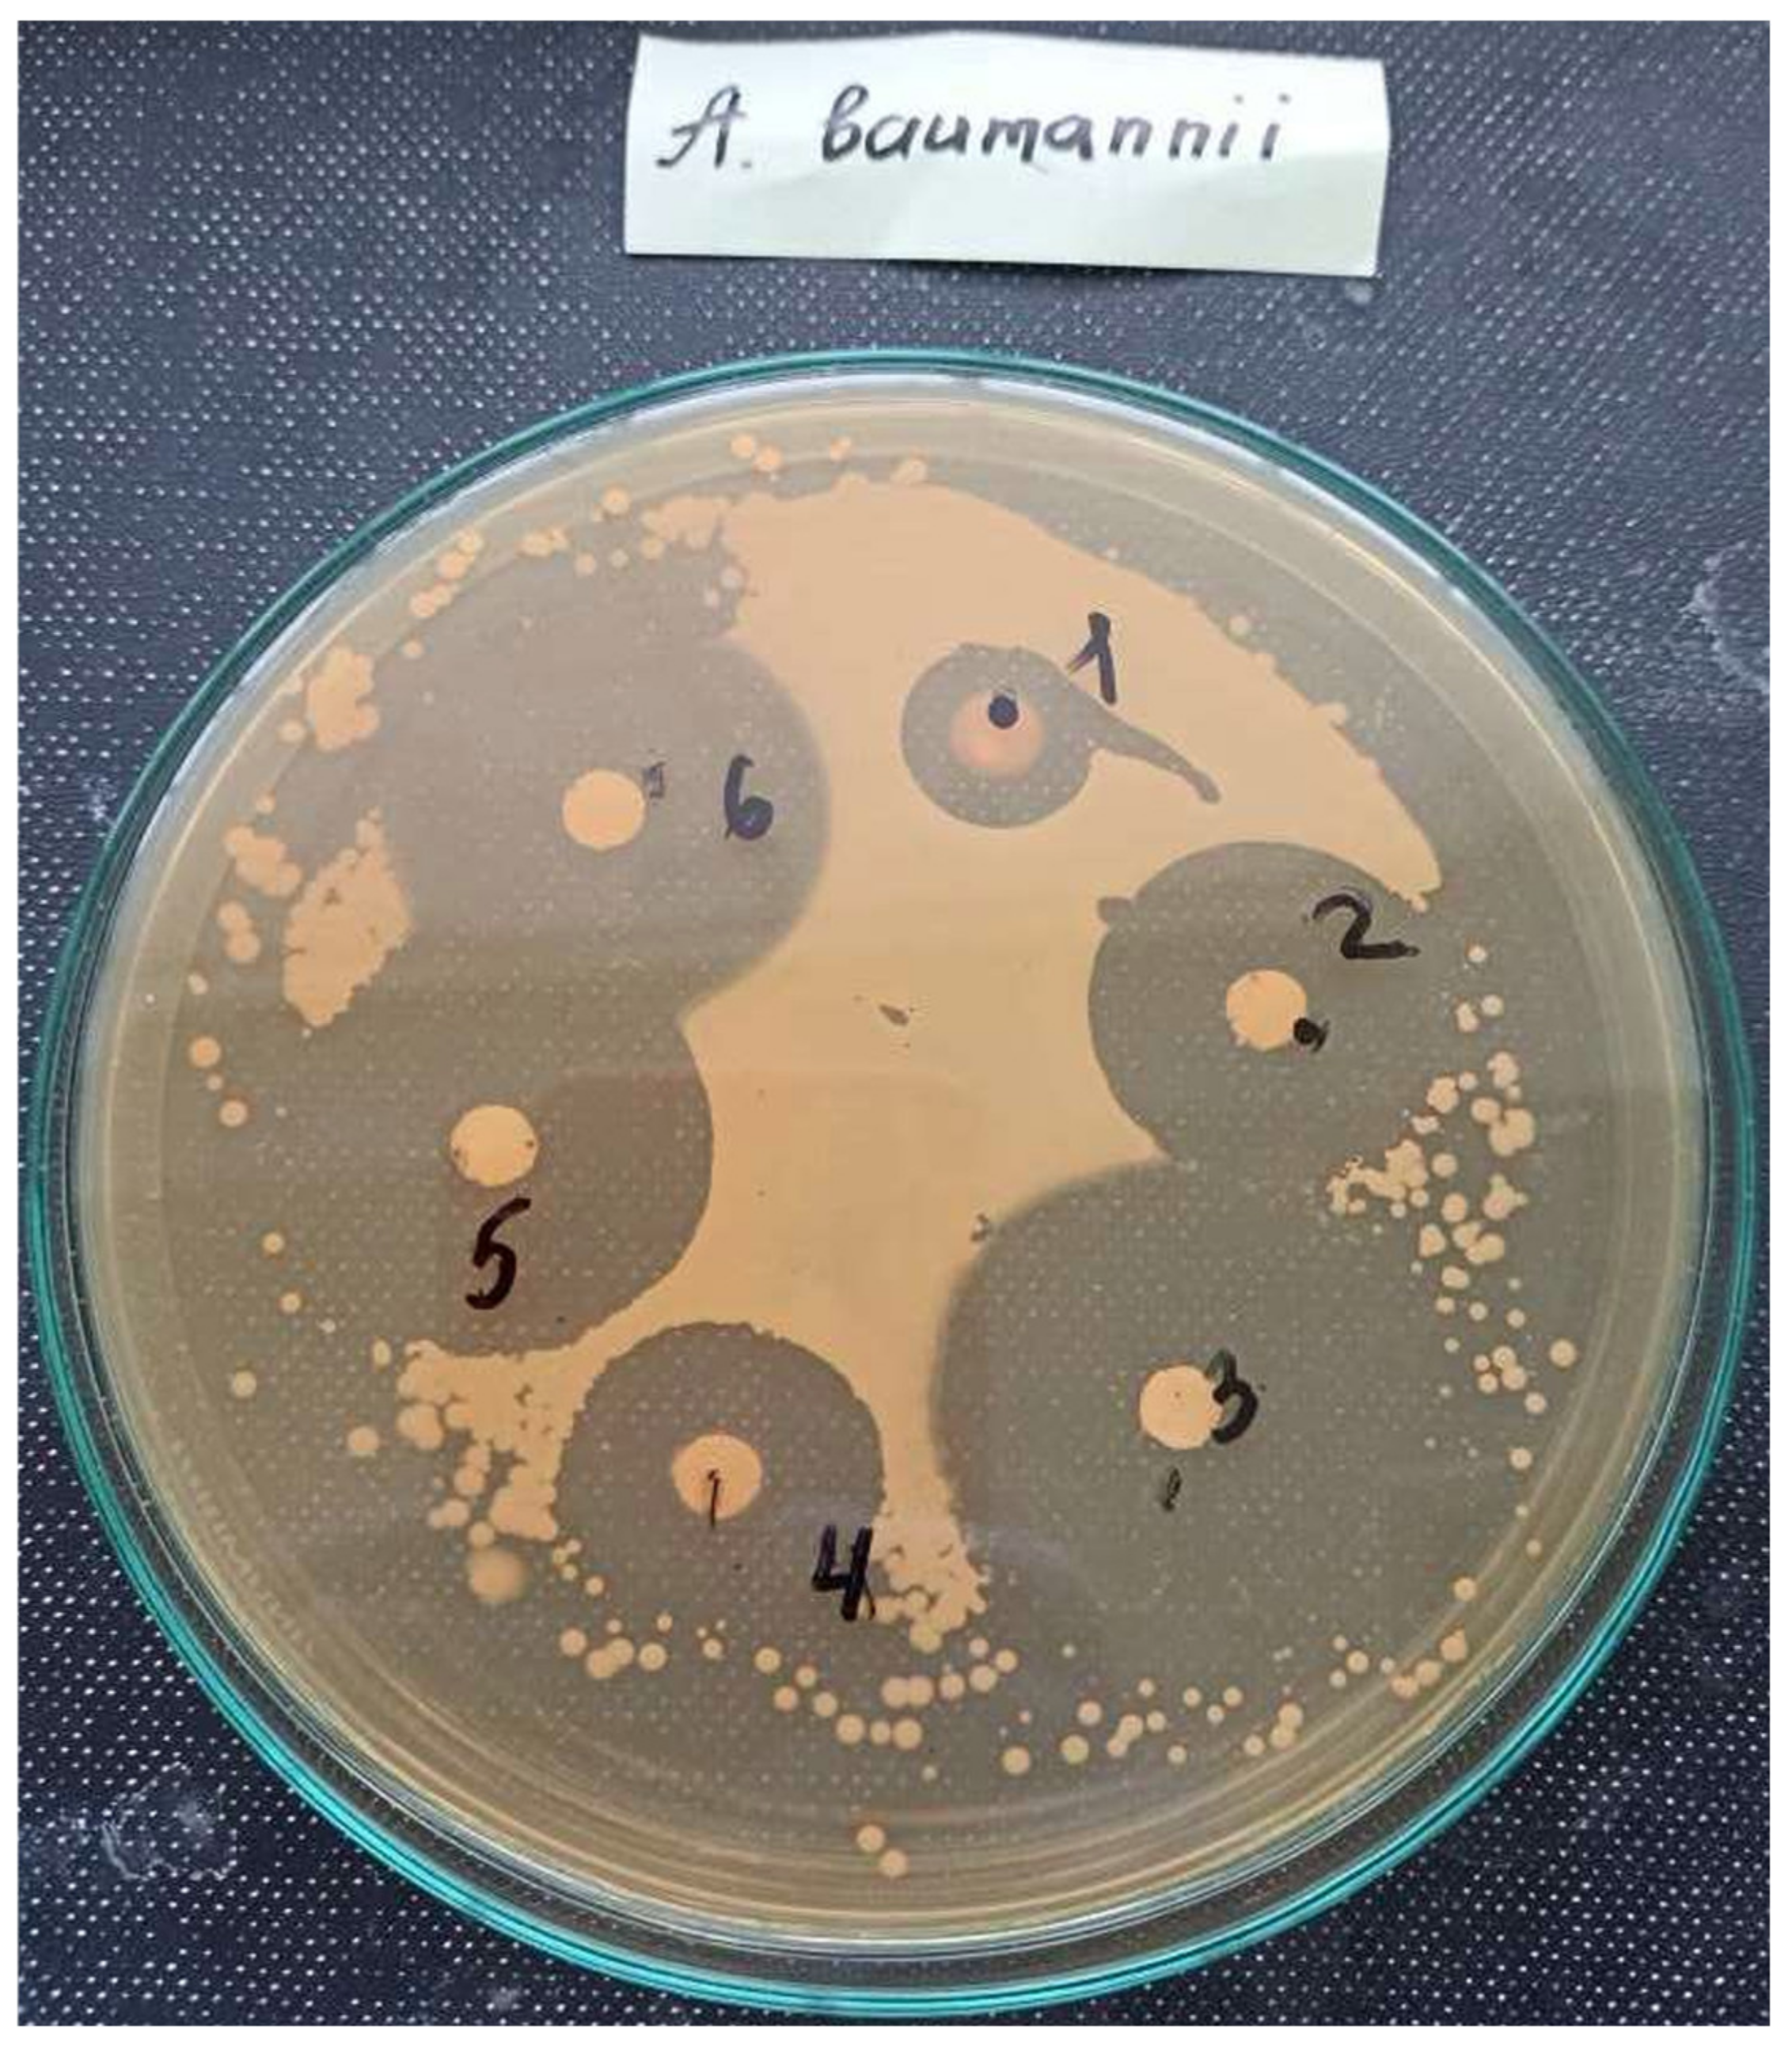

Theoretical and Experimental Studies of Phosphonium Ionic Liquids as Potential Antibacterials of MDR Acinetobacter baumannii
Abstract
:1. Introduction
2. Materials and Methods
2.1. QSAR Modeling of Antioxidant Activity
2.1.1. Dataset
2.1.2. QSAR
Descriptors
2.2. Biology
2.2.1. Antibacterial Activity Evaluation
2.2.2. Antioxidant Activity Evaluation
3. Results
3.1. Regression Model to Predict the Antioxidant Activity
| N | Method | Training Set a | Test Set a | ||
|---|---|---|---|---|---|
| q2 | MAEc | q2 | MAE | ||
| 1 | Transformer CNN | 0.77 ± 0.02 | 0.3 ± 0.01 | 0.75 ± 0.05 | 0.28 ± 0.02 |
| 2 | Transformer CNF | 0.76 ± 0.02 | 0.3 ± 0.01 | 0.77 ± 0.04 | 0.28 ± 0.02 |
| 3 | RF | 0.73 ± 0.02 | 0.32 ± 0.01 | 0.72 ± 0.04 | 0.3 ± 0.02 |
| 4 | Consensusb | 0.77 ± 0.02 | 0.29 ± 0.01 | 0.77 ± 0.04 | 0.27 ± 0.02 |
3.2. Selection of Compounds with the Help of In Silico Tools
3.3. Synthesis of PILs
3.3.1. Initial Materials and Structure Confirmation
3.3.2. Synthesis of Ionic Liquids
- Octyl(triphenyl)phosphonium bromide (PPh3C8–Br), CASRN 42036-78-2.Colorless solid, m.p.: 61–63 °C.1H NMR (400 MHz, DMSO-d6): σ = 0.81 (t, 3H, CH3), 1.19 (m, 8H, CH2), 1.48 (m, 4H, PCH2CH2CH2CH2), 3.56 (m, 2H, PCH2), 7.76–7.84 (m, 15H, Ar–H).
- Decyl(triphenyl)phosphonium bromide (PPh3C10–Br), CASRN 32339-43-8.White solid, m.p.: 86–88 °C.1H NMR (400 MHz, DMSO-d6): σ = 0.83 (t, 3H, CH3), 1.2 (m, 12H, CH2), 1.46 (m, 4H, PCH2CH2CH2CH2), 3.6 (m, 2H, PCH2), 7.8–7.9 (m, 15H, Ar–H).
- Dodecyl(triphenyl)phosphonium bromide (PPh3C12–Br), CASRN 15510-55-1.White solid, m.p.: 89–92 °C.1H NMR (400 MHz, DMSO-d6): σ = 0.83 (t, 3H, CH3), 1.2 (m, 16H, CH2), 1.46 (m, 4H, PCH2CH2CH2CH2), 3.6 (m, 2H, PCH2), 7.8–7.9 (m, 15H, Ar–H).
- Octyl(tributyl)phosphonium bromide (PBu3C8–Br), CARSN 57702-65-5.Liquid.1H NMR (400 MHz, CDCl3): σ = 0.86 (t, 3H, CH3), 0.96 (t, 9H, CH2CH2CH2CH3), 1.24 (m, 8H, CH2), 1.51 (m, 16H, PCH2CH2CH2CH2), 2.44 (m, 8H, PCH2).
- Decyl(tributyl)phosphonium bromide (Pbu3C10–Br), CASRN 99045-50-8.Viscous liquid.1H NMR (400 MHz, CDCl3): σ = 0.85 (t, 3H, CH3), 0.96 (t, 9H, CH2CH2CH2CH3), 1.24 (m, 12H, CH2), 1.51 (m, 16H, PCH2CH2CH2CH2), 2.43 (m, 8H, PCH2).
- Dodecyl(tributyl)phosphonium bromide (Pbu3C12–Br), CASRN 15294-63-0.White solid, m.p.: 30–32 °C.1H NMR (400 MHz, CDCl3): σ = 0.86 (t, 3H, CH3), 0.96 (t, 9H, CH2CH2CH2CH3), 1.24 (m, 16H, CH2), 1.52 (m, 16H, PCH2CH2CH2CH2), 2.44 (m, 8H, PCH2).
3.4. In Vitro Evaluation of the Activity of the PILs
3.4.1. Antibacterial Activity
| N | Compound | Compound Content on a Disk (µmoles) | |||
|---|---|---|---|---|---|
| 0.01 | 0.05 | 0.25 | 1.25 | ||
| 1 | PPh3C8–Br | 8.1 ± 0.3 | 12.3 ± 0.6 | 15.5 ± 0.3 | 17.3 ± 0.6 |
| 2 | PPh3C10–Br | 20.4 ± 0.9 | 25.4 ± 0.3 | 28.6 ± 0.9 | 31.5 ± 0.6 |
| 3 | PPh3C12–Br | 26.2 ± 0.6 | 30.1 ± 0.6 | 34.4 ± 0.9 | 41.8 ± 0.9 |
| 4 | Pbu3C8–Br | 14.5 ± 0.3 | 18.8 ± 0.3 | 22.3 ± 0.6 | 26.1 ± 0.3 |
| 5 | Pbu3C10–Br | 20.7 ± 0.3 | 25.4 ± 0.6 | 31.3 ± 0.3 | 34.2 ± 0.3 |
| 6 | Pbu3C12–Br | 26.1 ± 0.6 | 30.3 ± 0.3 | 33.2 ± 0.6 | 36.6 ± 0.6 |
| 7 | Ampicillin, oxacillin, ceftriaxone | 6 ± 0.3 | 6 ± 0.3 | 6 ± 0.3 | 6 ± 0.3 |
3.4.2. Antioxidant Activity
| N | Compound | Inhibition Fate of MDA, % |
|---|---|---|
| 1 | PPh3C8–Br | 31.5 ± 2.0 |
| 2 | PPh3C10–Br | 34.2 ± 1.2 |
| 3 | PPh3C12–Br | 33.3 ± 1.5 |
| 4 | PPh3C8–Br | 31.5 ± 2.0 |
| 5 | PPh3C10–Br | 34.2 ± 1.2 |
| 6 | PBu3C12–Br | 33.1 ± 2.2 |
| Ionol a | 31.4 ± 2.5 | |
| 1% DMSO b | 14 ± 0.5 |
4. Discussion
5. Conclusions
Supplementary Materials
Author Contributions
Funding
Institutional Review Board Statement
Informed Consent Statement
Data Availability Statement
Conflicts of Interest
Abbreviations
| AOA | Antioxidant activity |
| CDK | Chemistry Development Kit |
| CFU | Colony-forming unit |
| CNF | Convolutional neural fingerprint |
| CNN | Convolutional neural network |
| ILs | Ionic liquids |
| MAE | Mean absolute error |
| MDR | Multidrug-resistant |
| OCHEM | Online chemical database and modeling environment |
| PILs | Phosphonium ionic liquids |
| QSAR | Quantitative structure–activity relationship |
| RF | Random forest |
References
- Chen, L.-K.; Kuo, S.-C.; Chang, K.-C.; Cheng, C.-C.; Yu, P.-Y.; Chang, C.-H.; Chen, T.-Y.; Tseng, C.-C. Clinical Antibiotic-Resistant Acinetobacter Baumannii Strains with Higher Susceptibility to Environmental Phages than Antibiotic-Sensitive Strains. Sci. Rep. 2017, 7, 6319. [Google Scholar] [CrossRef] [PubMed]
- Vázquez-López, R.; Solano-Gálvez, S.G.; Juárez Vignon-Whaley, J.J.; Abello Vaamonde, J.A.; Padró Alonzo, L.A.; Rivera Reséndiz, A.; Muleiro Álvarez, M.; Vega López, E.N.; Franyuti-Kelly, G.; Álvarez-Hernández, D.A.; et al. Acinetobacter Baumannii Resistance: A Real Challenge for Clinicians. Antibiotics 2020, 9, 205. [Google Scholar] [CrossRef] [PubMed]
- Namiganda, V.; Mina, Y.; Meklat, A.; Touati, D.; Bouras, N.; Barakate, M.; Sabaou, N. Antibiotic Resistance Pattern of Acinetobacter Baumannii Strains Isolated from Different Clinical Specimens and Their Sensibility Against Bioactive Molecules Produced by Actinobacteria. Arab. J. Sci. Eng. 2019, 44, 6267–6275. [Google Scholar] [CrossRef]
- Wong, D.; Nielsen, T.B.; Bonomo, R.A.; Pantapalangkoor, P.; Luna, B.; Spellberg, B. Clinical and Pathophysiological Overview of Acinetobacter Infections: A Century of Challenges. Clin. Microbiol. Rev. 2017, 30, 409–447. [Google Scholar] [CrossRef] [Green Version]
- Nazarov, P.A.; Sorochkina, A.I.; Karakozova, M.V. New Functional Criterion for Evaluation of Homologous MDR Pumps. Front. Microbiol. 2020, 11, 2844. [Google Scholar] [CrossRef]
- Łuczak, J.; Jungnickel, C.; Łącka, I.; Stolte, S.; Hupka, J. Antimicrobial and Surface Activity of 1-Alkyl-3-Methylimidazolium Derivatives. Green Chem. 2010, 12, 593–601. [Google Scholar] [CrossRef]
- Cornellas, A.; Perez, L.; Comelles, F.; Ribosa, I.; Manresa, A.; Garcia, M.T. Self-Aggregation and Antimicrobial Activity of Imidazolium and Pyridinium Based Ionic Liquids in Aqueous Solution. J. Colloid Interface Sci. 2011, 355, 164–171. [Google Scholar] [CrossRef]
- Hodyna, D.; Kovalishyn, V.; Rogalsky, S.; Blagodatnyi, V.; Petko, K.; Metelytsia, L. Antibacterial Activity of Imidazolium-Based Ionic Liquids Investigated by QSAR Modeling and Experimental Studies. Chem. Biol. Drug Des. 2016, 88, 422–433. [Google Scholar] [CrossRef]
- Florio, W.; Becherini, S.; D’Andrea, F.; Lupetti, A.; Chiappe, C.; Guazzelli, L. Comparative Evaluation of Antimicrobial Activity of Different Types of Ionic Liquids. Mater. Sci. Eng. C 2019, 104, 109907. [Google Scholar] [CrossRef]
- Semenyuta, I.V.; Trush, M.M.; Kovalishyn, V.V.; Rogalsky, S.P.; Hodyna, D.M.; Karpov, P.; Xia, Z.; Tetko, I.V.; Metelytsia, L.O. Structure-Activity Relationship Modeling and Experimental Validation of the Imidazolium and Pyridinium Based Ionic Liquids as Potential Antibacterials of MDR Acinetobacter Baumannii and Staphylococcus Aureus. Int. J. Mol. Sci. 2021, 22, 563. [Google Scholar] [CrossRef]
- Schrekker, H.S.; Donato, R.K.; Fuentefria, A.M.; Bergamo, V.; Oliveira, L.F.; Machado, M.M. Imidazolium Salts as Antifungal Agents: Activity against Emerging Yeast Pathogens, without Human Leukocyte Toxicity. Med. Chem. Commun. 2013, 4, 1457–1460. [Google Scholar] [CrossRef]
- Bergamo, V.Z.; Donato, R.K.; Dalla Lana, D.F.; Donato, K.J.Z.; Ortega, G.G.; Schrekker, H.S.; Fuentefria, A.M. Imidazolium Salts as Antifungal Agents: Strong Antibiofilm Activity against Multidrug-Resistant Candida Tropicalis Isolates. Lett. Appl. Microbiol. 2015, 60, 66–71. [Google Scholar] [CrossRef]
- Reddy, G.K.K.; Nancharaiah, Y.V.; Venugopalan, V.P. Long Alkyl-Chain Imidazolium Ionic Liquids: Antibiofilm Activity against Phototrophic Biofilms. Colloids Surf. B Biointerfaces 2017, 155, 487–496. [Google Scholar] [CrossRef]
- Atefi, F.; Garcia, M.T.; Singer, R.D.; Scammells, P.J. Phosphonium Ionic Liquids: Design, Synthesis and Evaluation of Biodegradability. Green Chem. 2009, 11, 1595–1604. [Google Scholar] [CrossRef] [Green Version]
- Kanazawa, A.; Ikeda, T.; Endo, T. Synthesis and Antimicrobial Activity of Dimethyl- and Trimethyl-Substituted Phosphonium Salts with Alkyl Chains of Various Lengths. Antimicrob. Agents Chemother. 1994, 38, 945–952. [Google Scholar] [CrossRef] [Green Version]
- Cieniecka-Rosłonkiewicz, A.; Pernak, J.; Kubis-Feder, J.; Ramani, A.; Robertson, A.J.; Seddon, K.R. Synthesis, Anti-Microbial Activities and Anti-Electrostatic Properties of Phosphonium-Based Ionic Liquids. Green Chem. 2005, 7, 855–862. [Google Scholar] [CrossRef]
- O’Toole, G.A.; Wathier, M.; Zegans, M.E.; Shanks, R.M.Q.; Kowalski, R.; Grinstaff, M.W. Diphosphonium Ionic Liquids as Broad-Spectrum Antimicrobial Agents. Cornea 2012, 31, 810–816. [Google Scholar] [CrossRef] [Green Version]
- Wylie, M.P.; Bell, S.E.J.; Nockemann, P.; Bell, R.; McCoy, C.P. Phosphonium Ionic Liquid-Infused Poly(Vinyl Chloride) Surfaces Possessing Potent Antifouling Properties. ACS Omega 2020, 5, 7771–7781. [Google Scholar] [CrossRef]
- Ermolaev, V.V.; Arkhipova, D.M.; Miluykov, V.A.; Lyubina, A.P.; Amerhanova, S.K.; Kulik, N.V.; Voloshina, A.D.; Ananikov, V.P. Sterically Hindered Quaternary Phosphonium Salts (QPSs): Antimicrobial Activity and Hemolytic and Cytotoxic Properties. Int. J. Mol. Sci. 2022, 23, 86. [Google Scholar] [CrossRef]
- Kumar, V.; Malhotra, S.V. Antitumor Activity of Ionic Liquids on Human Tumor Cell Lines. In Ionic Liquid Applications: Pharmaceuticals, Therapeutics, and Biotechnology; ACS Symposium Series; American Chemical Society: Washington, DC, USA, 2010; Volume 1038, pp. 91–102. ISBN 9780841225473. [Google Scholar]
- Kumar, V.; Malhotra, S.V. Study on the Potential Anti-Cancer Activity of Phosphonium and Ammonium-Based Ionic Liquids. Bioorg. Med. Chem. Lett. 2009, 19, 4643–4646. [Google Scholar] [CrossRef]
- Choi, S.Y.; Rodríguez, H.; Gunaratne, H.Q.N.; Puga, A.V.; Gilpin, D.; McGrath, S.; Vyle, J.S.; Tunney, M.M.; Rogers, R.D.; McNally, T. Dual Functional Ionic Liquids as Antimicrobials and Plasticisers for Medical Grade PVCs. RSC Adv. 2014, 4, 8567–8581. [Google Scholar] [CrossRef]
- Okoro, C.C. The Biocidal Efficacy of Tetrakis-Hydroxymethyl Phosphonium Sulfate (THPS) Based Biocides on Oil Pipeline PigRuns Liquid Biofilms. Pet. Sci. Technol. 2015, 33, 1366–1372. [Google Scholar] [CrossRef]
- Knorre, D.A.; Markova, O.V.; Smirnova, E.A.; Karavaeva, I.E.; Sokolov, S.S.; Severin, F.F. Dodecyltriphenylphosphonium Inhibits Multiple Drug Resistance in the Yeast Saccharomyces Cerevisiae. Biochem. Biophys. Res. Commun. 2014, 450, 1481–1484. [Google Scholar] [CrossRef]
- Galkina, K.V.; Besedina, E.G.; Zinovkin, R.A.; Severin, F.F.; Knorre, D.A. Penetrating Cations Induce Pleiotropic Drug Resistance in Yeast. Sci. Rep. 2018, 8, 8131. [Google Scholar] [CrossRef]
- Nazarov, P.A.; Osterman, I.A.; Tokarchuk, A.V.; Karakozova, M.V.; Korshunova, G.A.; Lyamzaev, K.G.; Skulachev, M.V.; Kotova, E.A.; Skulachev, V.P.; Antonenko, Y.N. Mitochondria-Targeted Antioxidants as Highly Effective Antibiotics. Sci. Rep. 2017, 7, 1394. [Google Scholar] [CrossRef]
- Trush, M.M.; Kovalishyn, V.; Hodyna, D.; Golovchenko, O.V.; Chumachenko, S.; Tetko, I.V.; Brovarets, V.S.; Metelytsia, L. In Silico and in Vitro Studies of a Number PILs as New Antibacterials against MDR Clinical Isolate Acinetobacter Baumannii. Chem. Biol. Drug Des. 2020, 95, 624–630. [Google Scholar] [CrossRef]
- Eze, E.C.; Chenia, H.Y.; Zowalaty, M.E.E. Acinetobacter Baumannii Biofilms: Effects of Physicochemical Factors, Virulence, Antibiotic Resistance Determinants, Gene Regulation, and Future Antimicrobial Treatments. Infect. Drug Resist. 2018, 11, 2277–2299. [Google Scholar] [CrossRef] [Green Version]
- Qi, L.; Li, H.; Zhang, C.; Liang, B.; Li, J.; Wang, L.; Du, X.; Liu, X.; Qiu, S.; Song, H. Relationship between Antibiotic Resistance, Biofilm Formation, and Biofilm-Specific Resistance in Acinetobacter Baumannii. Front. Microbiol. 2016, 7, 483. [Google Scholar] [CrossRef] [PubMed] [Green Version]
- Ong, K.S.; Mawang, C.I.; Daniel-Jambun, D.; Lim, Y.Y.; Lee, S.M. Current Anti-Biofilm Strategies and Potential of Antioxidants in Biofilm Control. Expert Rev. Anti-Infect. Ther. 2018, 16, 855–864. [Google Scholar] [CrossRef] [PubMed]
- Gambino, M.; Cappitelli, F. Mini-Review: Biofilm Responses to Oxidative Stress. Biofouling 2016, 32, 167–178. [Google Scholar] [CrossRef] [PubMed]
- Deene, Y.D.; Hurley, C.; Venning, A.; Vergote, K.; Mather, M.; Healy, B.J.; Baldock, C. A Basic Study of Some Normoxic Polymer Gel Dosimeters. Phys. Med. Biol. 2002, 47, 3441–3463. [Google Scholar] [CrossRef]
- Jirasek, A.; Hilts, M.; Shaw, C.; Baxter, P. Investigation of Tetrakis Hydroxymethyl Phosphonium Chloride as an Antioxidant for Use in X-Ray Computed Tomography Polyacrylamide Gel Dosimetry. Phys. Med. Biol. 2006, 51, 1891–1906. [Google Scholar] [CrossRef]
- Sushko, I.; Novotarskyi, S.; Körner, R.; Pandey, A.K.; Rupp, M.; Teetz, W.; Brandmaier, S.; Abdelaziz, A.; Prokopenko, V.V.; Tanchuk, V.Y.; et al. Online Chemical Modeling Environment (OCHEM): Web Platform for Data Storage, Model Development and Publishing of Chemical Information. J. Comput. Aided Mol. Des. 2011, 25, 533–554. [Google Scholar] [CrossRef] [Green Version]
- Karpov, P.; Godin, G.; Tetko, I.V. Transformer-CNN: Swiss Knife for QSAR Modeling and Interpretation. J. Cheminform. 2020, 12, 17. [Google Scholar] [CrossRef] [Green Version]
- Tetko, I.V.; Karpov, P.; Bruno, E.; Kimber, T.B.; Godin, G. Augmentation Is What You Need! In Proceedings of the Artificial Neural Networks and Machine Learning—ICANN 2019: Workshop and Special Sessions; Tetko, I.V., Kůrková, V., Karpov, P., Theis, F., Eds.; Springer International Publishing: Cham, Switzerland, 2019; pp. 831–835. [Google Scholar]
- Breiman, L. Random Forests. Mach. Learn. 2001, 45, 5–32. [Google Scholar] [CrossRef] [Green Version]
- Hall, L.H.; Kier, L.B. Electrotopological State Indices for Atom Types: A Novel Combination of Electronic, Topological, and Valence State Information. J. Chem. Inf. Comput. Sci. 1995, 35, 1039–1045. [Google Scholar] [CrossRef]
- Tetko, I.V.; Tanchuk, V.Y. Application of Associative Neural Networks for Prediction of Lipophilicity in ALOGPS 2.1 Program. J. Chem. Inf. Comput. Sci. 2002, 42, 1136–1145. [Google Scholar] [CrossRef]
- Tetko, I.V.; Tanchuk, V.Y.; Kasheva, T.N.; Villa, A.E. Estimation of Aqueous Solubility of Chemical Compounds Using E-State Indices. J. Chem. Inf. Comput. Sci. 2001, 41, 1488–1493. [Google Scholar] [CrossRef]
- Willighagen, E.L.; Mayfield, J.W.; Alvarsson, J.; Berg, A.; Carlsson, L.; Jeliazkova, N.; Kuhn, S.; Pluskal, T.; Rojas-Chertó, M.; Spjuth, O.; et al. The Chemistry Development Kit (CDK) v2.0: Atom Typing, Depiction, Molecular Formulas, and Substructure Searching. J. Cheminform. 2017, 9, 33. [Google Scholar] [CrossRef] [Green Version]
- Bjerrum, E.J. SMILES Enumeration as Data Augmentation for Neural Network Modeling of Molecules. arXiv 2017, arXiv:1703.07076. [Google Scholar]
- Whitley, D.C.; Ford, M.G.; Livingstone, D.J. Unsupervised Forward Selection: A Method for Eliminating Redundant Variables. J. Chem. Inf. Comput. Sci. 2000, 40, 1160–1168. [Google Scholar] [CrossRef]
- Tetko, I.V.; Sushko, I.; Pandey, A.K.; Zhu, H.; Tropsha, A.; Papa, E.; Oberg, T.; Todeschini, R.; Fourches, D.; Varnek, A. Critical Assessment of QSAR Models of Environmental Toxicity against Tetrahymena Pyriformis: Focusing on Applicability Domain and Overfitting by Variable Selection. J. Chem. Inf. Model. 2008, 48, 1733–1746. [Google Scholar] [CrossRef] [Green Version]
- Sushko, I.; Novotarskyi, S.; Körner, R.; Pandey, A.K.; Kovalishyn, V.V.; Prokopenko, V.V.; Tetko, I.V. Applicability Domain for in Silico Models to Achieve Accuracy of Experimental Measurements. J. Chemom. 2010, 24, 202–208. [Google Scholar] [CrossRef]
- OCHEM Introduction-OCHEM User’s Manual-OCHEM Docs. Available online: http://docs.ochem.eu//display/MAN.html (accessed on 27 November 2021).
- Bauer, A.W.; Kirby, W.M.; Sherris, J.C.; Turck, M. Antibiotic Susceptibility Testing by a Standardized Single Disk Method. Am. J. Clin. Pathol. 1966, 45, 493–496. [Google Scholar] [CrossRef] [PubMed]
- Eloff, J.N. Sensitive and Quick Microplate Method to Determine the Minimal Inhibitory Concentration of Plant Extracts for Bacteria. Planta med. 1998, 64, 711–713. [Google Scholar] [CrossRef] [PubMed] [Green Version]
- Esterbauer, H.; Cheeseman, K.H. Determination of Aldehydic Lipid Peroxidation Products: Malonaldehyde and 4-Hydroxynonenal. In Methods in Enzymology; Academic Press: Cambridge, MA, USA, 1990; Volume 186, pp. 407–421. ISBN 00766879. [Google Scholar]
- Papastergiadis, A.; Mubiru, E.; Van Langenhove, H.; De Meulenaer, B. Malondialdehyde Measurement in Oxidized Foods: Evaluation of the Spectrophotometric Thiobarbituric Acid Reactive Substances (TBARS) Test in Various Foods. J. Agric. Food Chem. 2012, 60, 9589–9594. [Google Scholar] [CrossRef] [PubMed]
- Sushko, I.; Salmina, E.; Potemkin, V.A.; Poda, G.; Tetko, I.V. ToxAlerts: A Web Server of Structural Alerts for Toxic Chemicals and Compounds with Potential Adverse Reactions. J. Chem. Inf. Model. 2012, 52, 2310–2316. [Google Scholar] [CrossRef]
- Phongpaichit, S.; Nikom, J.; Rungjindamai, N.; Sakayaroj, J.; Hutadilok-Towatana, N.; Rukachaisirikul, V.; Kirtikara, K. Biological Activities of Extracts from Endophytic Fungi Isolated from Garcinia Plants. FEMS Immunol. Med. Microbiol. 2007, 51, 517–525. [Google Scholar] [CrossRef] [Green Version]
- Chua, S.L.; Ding, Y.; Liu, Y.; Cai, Z.; Zhou, J.; Swarup, S.; Drautz-Moses, D.I.; Schuster, S.C.; Kjelleberg, S.; Givskov, M.; et al. Reactive Oxygen Species Drive Evolution of Pro-Biofilm Variants in Pathogens by Modulating Cyclic-Di-GMP Levels. Open Biol. 2016, 6, 160162. [Google Scholar] [CrossRef] [Green Version]
- Grant, S.S.; Hung, D.T. Persistent Bacterial Infections, Antibiotic Tolerance, and the Oxidative Stress Response. Virulence 2013, 4, 273–283. [Google Scholar] [CrossRef] [Green Version]
- Yehye, W.A.; Rahman, N.A.; Ariffin, A.; Abd Hamid, S.B.; Alhadi, A.A.; Kadir, F.A.; Yaeghoobi, M. Understanding the Chemistry behind the Antioxidant Activities of Butylated Hydroxytoluene (BHT): A Review. Eur. J. Med. Chem. 2015, 101, 295–312. [Google Scholar] [CrossRef]
- Tauber, J.; Imbri, D.; Opatz, T. Radical Addition to Iminium Ions and Cationic Heterocycles. Molecules 2014, 19, 6190. [Google Scholar] [CrossRef]
- Egorova, K.S.; Gordeev, E.G.; Ananikov, V.P. Biological Activity of Ionic Liquids and Their Application in Pharmaceutics and Medicine. Chem. Rev. 2017, 117, 7132–7189. [Google Scholar] [CrossRef]
- Curreri, A.M.; Mitragotri, S.; Tanner, E.E.L. Recent Advances in Ionic Liquids in Biomedicine. Adv. Sci. 2021, 8, 2004819. [Google Scholar] [CrossRef]
- Nikfarjam, N.; Ghomi, M.; Agarwal, T.; Hassanpour, M.; Sharifi, E.; Khorsandi, D.; Ali Khan, M.; Rossi, F.; Rossetti, A.; Nazarzadeh Zare, E.; et al. Antimicrobial Ionic Liquid-Based Materials for Biomedical Applications. Adv. Funct. Mater. 2021, 31, 2104148. [Google Scholar] [CrossRef]
- Farghaly, T.A.; Abdalla, M.M. Synthesis, Tautomerism, and Antimicrobial, Anti-HCV, Anti-SSPE, Antioxidant, and Antitumor Activities of Arylazobenzosuberones. Bioorg. Med. Chem. 2009, 17, 8012–8019. [Google Scholar] [CrossRef]
- Ferreira, I.C.F.R.; Heleno, S.A.; Reis, F.S.; Stojkovic, D.; Queiroz, M.J.R.P.; Vasconcelos, M.H.; Sokovic, M. Chemical Features of Ganoderma Polysaccharides with Antioxidant, Antitumor and Antimicrobial Activities. Spec. Issue Ganoderma Phytochem. 2015, 114, 38–55. [Google Scholar] [CrossRef] [Green Version]
- Kartashova, O.L.; Utkina, T.M.; Zhestkov, A.V.; Kurkin, V.A.; Zolotarev, P.N. Effect of phytosubstances with antioxidant activity on persistence properties of microorganisms. Antibiot. Chemoter. 2009, 54, 16–18. [Google Scholar]
- Angiolella, L.; Sacchetti, G.; Efferth, T. Antimicrobial and Antioxidant Activities of Natural Compounds. Evid.-Based Complement. Alternat. Med. 2018, 2018, 1945179. [Google Scholar] [CrossRef]
- Parham, S.; Kharazi, A.Z.; Bakhsheshi-Rad, H.R.; Nur, H.; Ismail, A.F.; Sharif, S.; RamaKrishna, S.; Berto, F. Antioxidant, Antimicrobial and Antiviral Properties of Herbal Materials. Antioxidants 2020, 9, 1309. [Google Scholar] [CrossRef]
- Özgeriş, B. Design, Synthesis, Characterization, and Biological Evaluation of Nicotinoyl Thioureas as Antimicrobial and Antioxidant Agents. J. Antibiot. 2021, 74, 233–243. [Google Scholar] [CrossRef]
- Tetko, I.V. Associative Neural Network. Methods Mol. Biol. Clifton NJ 2008, 458, 185–202. [Google Scholar] [CrossRef] [Green Version]
- Frank, E.; Hall, M.; Trigg, L.; Holmes, G.; Witten, I.H. Data Mining in Bioinformatics Using Weka. Bioinformatics 2004, 20, 2479–2481. [Google Scholar] [CrossRef] [Green Version]
- N-Octyl Triphenylphosphonium Bromide. Available online: https://www.chemsrc.com/en/cas/42036-78-2_799327.html (accessed on 18 February 2022).
- Kuz’menok, N.M.; Mikhalyonok, S.G.; Arol, A.S.; Shevchuk, M.O.; Bezborodov, V.S.; Krakhalev, M.N.; Sutormin, V.S.; Prishchepa, O.O.; Zharkova, G.M.; Zyryanov, V.Y. Synthesis of Organotriphenylphosphonium Halides, Quaternary Ammonium Salts and Study of Their Application as Surfactants Soluble in Liquid Crystals. Zhidkie Krist. Ikh Prakt. Ispolzovanie 2020, 20, 6–18. [Google Scholar] [CrossRef]
- Decyl-TPP. Available online: https://www.chemsrc.com/en/cas/32339-43-8_255481.html (accessed on 18 February 2022).
- Ivashchenko, S.P. Lipids. XLIV. A New Synthesis of 1-Alken-1-Yl Alkyl Ethers Using the Wittig Reaction. Zh. Org. Khimii. 1966, 2, 2181–2183. [Google Scholar]
- Kurt, M. Antiseptic Detergent Compositions. Avaialble online: https://patents.google.com/patent/US3281365A (accessed on 1 April 2022).
- Tributyl(Dodecyl)Phosphonium Bromide. Available online: https://www.chemsrc.com/en/cas/15294-63-0_1102483.html (accessed on 19 February 2022).

| PILs | Compound | Molecular Weight | Chemical Structure | Chemical Name |
|---|---|---|---|---|
| 1 | PPh3C8–Br | 455.41 |  | Octyl(triphenyl)phosphonium bromide |
| 2 | PPh3C10–Br | 483.46 |  | Decyl(triphenyl)phosphonium bromide |
| 3 | PPh3C12–Br | 511.52 |  | Dodecyl(triphenyl)phosphonium bromide |
| 4 | PBu3C8–Br | 395.4 |  | Octyl(tributyl)phosphonium bromide |
| 5 | PBu3C10–Br | 423.49 |  | Decyl(tributyl)phosphonium bromide |
| 6 | PBu3C12–Br | 451.55 |  | Dodecyl(tributyl)phosphonium bromide |
Publisher’s Note: MDPI stays neutral with regard to jurisdictional claims in published maps and institutional affiliations. |
© 2022 by the authors. Licensee MDPI, Basel, Switzerland. This article is an open access article distributed under the terms and conditions of the Creative Commons Attribution (CC BY) license (https://creativecommons.org/licenses/by/4.0/).
Share and Cite
Metelytsia, L.O.; Hodyna, D.M.; Semenyuta, I.V.; Kovalishyn, V.V.; Rogalsky, S.P.; Derevianko, K.Y.; Brovarets, V.S.; Tetko, I.V. Theoretical and Experimental Studies of Phosphonium Ionic Liquids as Potential Antibacterials of MDR Acinetobacter baumannii. Antibiotics 2022, 11, 491. https://doi.org/10.3390/antibiotics11040491
Metelytsia LO, Hodyna DM, Semenyuta IV, Kovalishyn VV, Rogalsky SP, Derevianko KY, Brovarets VS, Tetko IV. Theoretical and Experimental Studies of Phosphonium Ionic Liquids as Potential Antibacterials of MDR Acinetobacter baumannii. Antibiotics. 2022; 11(4):491. https://doi.org/10.3390/antibiotics11040491
Chicago/Turabian StyleMetelytsia, Larysa O., Diana M. Hodyna, Ivan V. Semenyuta, Vasyl V. Kovalishyn, Sergiy P. Rogalsky, Kateryna Yu Derevianko, Volodymyr S. Brovarets, and Igor V. Tetko. 2022. "Theoretical and Experimental Studies of Phosphonium Ionic Liquids as Potential Antibacterials of MDR Acinetobacter baumannii" Antibiotics 11, no. 4: 491. https://doi.org/10.3390/antibiotics11040491
APA StyleMetelytsia, L. O., Hodyna, D. M., Semenyuta, I. V., Kovalishyn, V. V., Rogalsky, S. P., Derevianko, K. Y., Brovarets, V. S., & Tetko, I. V. (2022). Theoretical and Experimental Studies of Phosphonium Ionic Liquids as Potential Antibacterials of MDR Acinetobacter baumannii. Antibiotics, 11(4), 491. https://doi.org/10.3390/antibiotics11040491






